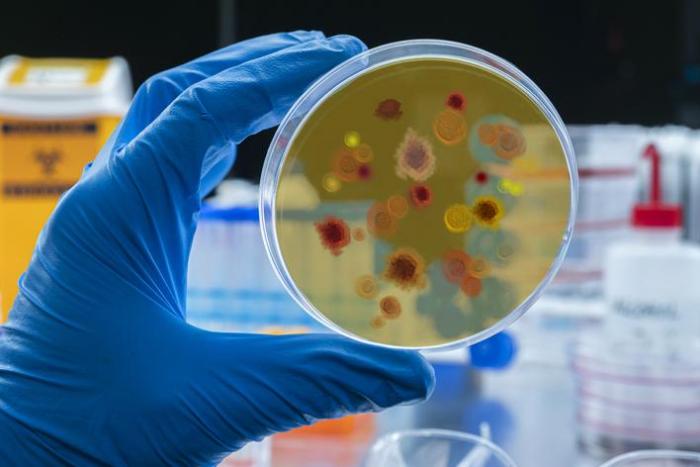
course-premium

MÁSTER EN EPIDEMIOLOGÍA Y PREVENCIÓN DE ENFERMEDADES
-
Me siento mucho mas preparada como profesional. Recomendado.
← | →
-
Interesante todo lo que aprendi con este master. Recomiendo esta escuela, ha sido muy seria en todo momento.
← | →
Master
Online

¿Necesitas un coach de formación?
Te ayudará a comparar y elegir el mejor curso para ti y a financiar tu matrícula en cómodos plazos.
Conoce las claves de la epidemiología
-
Tipología
Master
-
Metodología
Online
-
Horas lectivas
600h
-
Duración
1 Año
-
Campus online
Sí
-
Envío de materiales de aprendizaje
Sí
El Programa está especialmente diseñado para aquellas personas que estén interesadas en adquirir conocimientos sobre Epidemiología y Prevención de Enfermedades y que quieran asegurarse un recorrido ascendente en esta área, con una especial elevación y consolidación de competencias.
La Salud Pública se configura como una de las disciplinas más importantes de nuestra sociedad encargada de velar y mejorar la salud de las poblaciones a través de una serie de acciones y políticas que persiguen la consecución de una serie de hábitos de vida saludable. Es por eso que cada vez más se reclaman profesionales sanitarios de diferentes ramas capaces de trabajar en equipos multidisciplinares enfocados en la obtención de este objetivo. Además, al final de cada unidad didáctica el/la alumno/a encontrará ejercicios de autoevaluación para poder evaluar el nivel y los conocimientos adquiridos en cada apartado, y que él/ella mismo/a podrá corregir a través del solucionario adjunto de forma autónoma.
El alumno recibirá acceso a un curso inicial donde encontrará información sobre la metodología de aprendizaje, la titulación que recibirá, el funcionamiento del Campus Virtual, qué hacer una vez el alumno haya finalizado e información sobre Grupo Esneca Formación. Además, el alumno dispondrá de un servicio de clases en directo.
Información importante
Documentos
- ERG110.pdf
Precio a usuarios Emagister:
Instalaciones y fechas
Ubicación
Inicio
Inicio
A tener en cuenta
Una vez finalizados los estudios y superadas las pruebas de evaluación, el alumno recibirá un diploma que certifica el “MÁSTER EN EPIDEMIOLOGÍA Y PREVENCIÓN DE ENFERMEDADES”, de la Escuela Origen International Education, avalada por
nuestra condición de socios de la CECAP, máxima institución española en formación y de calidad.
Los diplomas, además, llevan el sello de Notario Europeo, que da fe de la validez, contenidos y autenticidad del título a nivel nacional e internacional.
Opiniones
-
Me siento mucho mas preparada como profesional. Recomendado.
← | →
-
Interesante todo lo que aprendi con este master. Recomiendo esta escuela, ha sido muy seria en todo momento.
← | →
Valoración del curso
Lo recomiendan
Valoración del Centro
Clara Lombardo
Frida Lugo
Logros de este Centro
Todos los cursos están actualizados
La valoración media es superior a 3,7
Más de 50 opiniones en los últimos 12 meses
Este centro lleva 7 años en Emagister.
Materias
- Prevención de riesgos
- Estudios epidemiológicos
- Primeros Auxilios
- Políticas de salud
- Educación para la salud
- Promoción de la salud
Profesores
Equipo Docente
Profesorado
Temario
PARTE 1
EPIDEMIOLOGÍA Y SALUD PÚBLICA
INTRODUCCIÓN
MÓDULO 1. SALUD Y ENFERMEDAD
UNIDAD DIDÁCTICA 1. CONCEPTO DE SALUD
1. Dimensiones de la salud
-Dimensión física
-Dimensión psicológica
-Dimensión sociocultural
2. Modelos explicativos
-Modelo ecológico
-Modelo biomédico
-Modelo biopsicosocial
UNIDAD DIDÁCTICA 2. CONCEPTO DE ENFERMEDAD
1. Tipos
-Según su duración
-Según su etiopatogenia
-Clasificación Internacional de Enfermedades (CIE-11)
2. Fases de la enfermedad
-Estado prepatogénico
-Estado patogénico
-Estado final
UNIDAD DIDÁCTICA 3. NECESIDADES DEL SER HUMANO
1. Jerarquía de las necesidades
2. Necesidades fisiológicas
UNIDAD DIDÁCTICA 4. PROTECCIÓN DE LA SALUD
1. Prevención primaria
2. Prevención secundaria
3. Prevención terciaria
MÓDULO 2. CARACTERIZACIÓN DE LA SALUD PÚBLICA
UNIDAD DIDÁCTICA 1. CONCEPTO DE SALUD PÚBLICA
UNIDAD DIDÁCTICA 2. EVOLUCIÓN HISTÓRICA
1. Antiguo Egipto
2. Antigüedad grecorromana
3. Edad Media
4. Ilustración
5. Siglo XIX
UNIDAD DIDÁCTICA 3. FUNCIONES DE LA SALUD PÚBLICA
1. Protección sanitaria
2. Promoción sanitaria
3. Restauración sanitaria
MÓDULO 3. DEMOGRAFÍA Y SALUD PÚBLICA
UNIDAD DIDÁCTICA 1. NOCIONES BÁSICAS SOBRE CIENCIA
DEMOGRÁFICA
1. Evolución histórica
-Censos romanos
-Papel de Ibn Jaldún
-Registros poblacionales en la Península Ibérica
-Fuentes contemporáneas
2. Tipos
-Demografía estática
-Demografía dinámica
3. Teorías
-Teoría de la transición demográfica
-Teoría de la segunda transición demográfica
-Teoría de la revolución reproductiva
4. Instrumentos demográficos
-Tablas de frecuencia
-Pirámides de población
-Densidad demográfica
5. Importancia de la demografía en la salud pública
UNIDAD DIDÁCTICA 2. HERRAMIENTAS DE LA SALUD PÚBLICA
1. Determinantes de salud
-Modelo de Laframboise y Lalonde
-Modelo de Tarlov
-Modelo de Dahlgren y Whitehead
2. Indicadores de salud
-Tasa de mortalidad general
-Tasa de mortalidad específica
-Tasa de mortalidad infantil
-Tasa de natalidad
-Tasa de morbilidad
-Esperanza de vida al nacer
-Índice de Swaroop
-Crecimiento vegetativo
MÓDULO 4. ADMINISTRACIÓN Y ORGANIZACIÓN SANITARIA
UNIDAD DIDÁCTICA 1. DERECHO A LA PROTECCIÓN DE LA SALUD
UNIDAD DIDÁCTICA 2. LEY GENERAL DE SANIDAD
1. Fundamentos del sistema de salud español
-Principios generales
-Actuaciones sanitarias
2. Competencias
-Competencias estatales
-Competencias autonómicas
-Competencias locales
3. Sistema sanitario público
-Sistema Nacional de Salud
-Servicios de salud autonómicos
-Consejo Interterritorial
UNIDAD DIDÁCTICA 3. NIVELES ASISTENCIALES
1. Atención primaria
2. Atención secundaria
3. Atención terciaria
UNIDAD DIDÁCTICA 4. INFRAESTRUCTURA HOSPITALARIA
1. Tipos de hospitales
MÓDULO 5. FUNDAMENTOS DE LA EPIDEMIOLOGÍA
UNIDAD DIDÁCTICA 1. CONCEPTO
1. Principios
2. Objetivos
3. Terminología específica
-Brote
-Incidencia
-Prevalencia
-Enfermedad endémica
-Epidemia
-Pandemia
-Riesgo relativo
-Riesgo atribuible
-Fracción etiológica de expuestos
-Fracción etiológica poblacional
-Odds ratio
4. Tipos de errores
-Sesgos de selección
-Sesgos de clasificación
-Sesgos de confusión
UNIDAD DIDÁCTICA 2. ENFOQUES EN EPIDEMIOLOGÍA
1. Epidemiología descriptiva
-Población de interés
2. Epidemiología analítica
-Estudio de los factores de riesgo
3. Epidemiología experimental
4. Epidemiología ecológica
UNIDAD DIDÁCTICA 3. CLASES DE ESTUDIOS EPIDEMIOLÓGICOS
1. Estudios descriptivos
2. Estudios analíticos
-Estudios de cohorte
-Estudios de caso-control
3. Ensayos clínicos
-Ensayos clínicos controlados aleatorizados
-Ensayos clínicos no controlados
UNIDAD DIDÁCTICA 4. ETIOLOGÍA DE LAS ENFERMEDADES
1. Modelo determinista de causalidad
2. Modelo probabilístico de causalidad
3. Modelo determinista modificado
4. Criterios de Bradford Hill
MÓDULO 6. VIGILANCIA EPIDEMIOLÓGICA
UNIDAD DIDÁCTICA 1. DEFINICIÓN
1. Beneficios de la vigilancia epidemiológica
UNIDAD DIDÁCTICA 2. TIPOS DE VIGILANCIA
1. Vigilancia pasiva
2. Vigilancia activa
3. Vigilancia centinela
4. Vigilancia sindrómica
UNIDAD DIDÁCTICA 3. RED NACIONAL DE VIGILANCIA EN ESPAÑA
1. Funciones y estructura básica
2. Declaración obligatoria de enfermedades
-Información microbiológica
3. Situaciones epidémicas
-Brote de interés supracomunitario
MÓDULO 7. EPIDEMIOLOGÍA EN ENFERMEDADES INFECCIOSAS
UNIDAD DIDÁCTICA 1. CONCEPTO
1. La transmisibilidad como rasgo distintivo
-Diferencia entre enfermedad infecciosa y contagiosa
2. Agentes biológicos patógenos
-Bacterias
-Virus
-Hongos
-Protozoos
-Priones
3. Zoonosis
4. Técnicas de diagnosis
-Diagnóstico por síntomas
-Cultivo microbiano
-Microscopio
-Test bioquímico
-PCR
-Secuenciación
UNIDAD DIDÁCTICA 2. CADENA EPIDEMIOLÓGICA
1. Agente infeccioso
2. Reservorio
3. Fuente de infección
4. Vía de transmisión
5. Huésped susceptible
6. Medidas de control
UNIDAD DIDÁCTICA 3. MEDIDAS DE PREVENCIÓN
MÓDULO 8. EPIDEMIOLOGÍA EN ENFERMEDADES RESPIRATORIAS
UNIDAD DIDÁCTICA 1. DEFINICIÓN
1. Anatomía y fisiología del aparato respiratorio
2. Tipos de patologías
-Infecciones respiratorias agudas
-Infecciones respiratorias crónicas
-Enfermedades obstructivas crónicas
-Enfermedades intersticiales pulmonares
3. Factores de riesgo
UNIDAD DIDÁCTICA 2. GRIPE
1. Tipos de virus
-Influenzavirus A
-Influenzavirus B
-Influenzavirus C
2. Signos y síntomas
3. Complicaciones
-Neumonía vírica
-Neumonía bacteriana
-Síndrome de Reye
4. Incidencia
UNIDAD DIDÁCTICA 3. SARS-CoV-2
1. Historia y pandemia de 2020
2. Ciclo infectivo y período de incubación
3. Signos y síntomas
4. Incidencia
UNIDAD DIDÁCTICA 4. MEDIDAS PREVENTIVAS
MÓDULO 9. EPIDEMIOLOGÍA EN ENFERMEDADES
CARDIOVASCULARES
UNIDAD DIDÁCTICA 1. CARACTERIZACIÓN
1. Estructura y funcionamiento del sistema cardiovascular
2. Tipos de patologías
-Fiebre reumática aguda
-Cardiopatías reumáticas crónicas
-Enfermedades hipertensivas
-Cardiopatía isquémica
-Enfermedad cardiopulmonar
-Enfermedades cerebrovasculares
-Enfermedades arteriales
-Enfermedades venosas
-Otras enfermedades
3. Factores de riesgo específicos
-Sedentarismo
-Dieta
-Hábitos de sueño
-Situación socioeconómica
-Depresión
-Estrés laboral
4. Afectación
UNIDAD DIDÁCTICA 2. MEDIDAS PREVENTIVAS
MÓDULO 10. EPIDEMIOLOGÍA DE LA OBESIDAD
UNIDAD DIDÁCTICA 1. ALTERACIONES DEL ESTADO NUTRICIONAL
1. Hiponutrición
2. Hipernutrición
-Obesidad
UNIDAD DIDÁCTICA 2. VALORACIÓN DEL ESTADO NUTRICIONAL
1. Valores antropométricos
-Peso corporal
-Estatura
-Índice de masa corporal
-Pliegues cutáneos
-Perímetro corporal
UNIDAD DIDÁCTICA 3. EPIDEMIOLOGÍA DESCRIPTIVA DE LA OBESIDAD
UNIDAD DIDÁCTICA 4. MEDIDAS PREVENTIVAS
1. Educación nutricional
MÓDULO 11. EPIDEMIOLOGÍA DE LA DIABETES
UNIDAD DIDÁCTICA 1. DEFINICIÓN
1. Tipos
-Diabetes tipo 1
-Diabetes tipo 2
-Diabetes gestacional
-Otros tipos de diabetes
2. Principales complicaciones
3. Prevalencia
UNIDAD DIDÁCTICA 2. TÉCNICAS DE DIAGNÓSTICO
1. Análisis clínicos
-Prueba de glucemia en ayunas
-Prueba de tolerancia a la glucosa oral
-Medición de la hemoglobina A1C
-Prueba aleatoria de glucemia en sangre
2. Estudios empíricos
-Examen de los antecedentes familiares
-Valoración de los factores de riesgo
-Análisis de los síntomas típicos de la diabetes
UNIDAD DIDÁCTICA 3. FACTORES DE RIESGO Y MEDIDAS DE
AUTOEVALUACIÓN
MÓDULO 12. EPIDEMIOLOGÍA DE LAS ENFERMEDADES DE
TRANSMISIÓN SEXUAL
UNIDAD DIDÁCTICA 1. CARACTERIZACIÓN
1. Prácticas de riesgo
2. Principales patologías
-Sífilis
-Gonorrea
-Clamidia
-Herpes genital
-VIH/Sida
-Hepatitis B
-Hepatitis C
-Virus del papiloma humano
-Candidiasis
-Tricomoniasis
-Sarna
3. Afectación
UNIDAD DIDÁCTICA 2. VIGILANCIA EPIDEMIOLÓGICA Y MEDIDAS DE
PREVENCIÓN
1. Sistema de Información por Infección de VIH de España
MÓDULO 13. EPIDEMIOLOGÍA DEL CÁNCER
UNIDAD DIDÁCTICA 1. APROXIMACIÓN AL CÁNCER
1. Concepto
2. Factores de riesgo y causas
UNIDAD DIDÁCTICA 2. TIPOS DE CÁNCER MÁS FRECUENTES
1. Cáncer de mama
2. Cáncer de pulmón
3. Cáncer de próstata
4. Cáncer de colon
5. Cáncer de vejiga
6. Cáncer de recto
7. Otros cánceres
UNIDAD DIDÁCTICA 3. DIAGNÓSTICO Y PREVENCIÓN
1. Importancia del diagnóstico precoz
MÓDULO 14. SALUD MEDIOAMBIENTAL
UNIDAD DIDÁCTICA 1. CONCEPTO DE MEDIOAMBIENTE
1. Relación entre salud y medioambiente
UNIDAD DIDÁCTICA 2. INDICADORES AMBIENTALES
1. Calidad del aire
-Medición de las partículas suspendidas en el aire
-Determinación de los niveles de gases contaminantes
-Cálculo de los compuestos orgánicos volátiles
-Detección de metales pesados
2. Calidad del agua
-pH
-Grado de turbidez
-Presencia de sólidos disueltos
-Detección de metales pesados
-Medición de los niveles de nitrógeno y fósforo
-Contaminación por bacterias y otros microorganismos
3. Biodiversidad
-Número de especies
-Endemismo
-Variedad de niveles tróficos
-Conectividad del hábitat y diversidad de hábitats
4. Degradación del suelo
-Erosión
-Compactación
-Pérdida de materia orgánica
-Salinización
-Contaminación
5. Ruido
-Nivel de decibelios
-Frecuencia y duración
-Tono, ritmo y timbre
-Horario
-Ubicación del emisor y del receptor
6. Contaminación lumínica
-Intensidad de la luz
-Direccionalidad de la luz
-Longitud de onda de la luz
-Uniformidad de la luz
-Duración
UNIDAD DIDÁCTICA 3. ESTRATEGIA EUROPEA DE SALUD AMBIENTAL
MÓDULO 15. PROMOCIÓN DE LA SALUD
UNIDAD DIDÁCTICA 1. NOCIONES BÁSICAS
1. Concepto
2. Conferencias Mundiales de Promoción de la Salud
3. Declaración de Yakarta
UNIDAD DIDÁCTICA 2. EDUCACIÓN SANITARIA
UNIDAD DIDÁCTICA 3. VACUNACIÓN
1. Evolución histórica de las vacunas
-Precedente turco y papel de Lady Mary Wortley Montagu
-Vacuna de Edward Jenner (1796)
-Vacunas de Pasteur (1880)
2. Etapas de desarrollo de una vacuna
-Fase de exploración
-Fase preclínica
-Fase de ensayo en humanos
-Fase de aprobación
-Fase de comercialización y actualización
3. Tipos de vacunas
-Vacunas vivas atenuadas
-Vacunas inactivadas
-Vacunas de toxoides
-Vacunas de subunidades
-Vacunas de vector recombinante
-Vacunas de ADN
-Vacunas de ARN
4. Calendario de vacunación
-Calendario en España
SOLUCIONARIO
BIBLIOGRAFÍA COMPLEMENTARIA
PARTE 2
PERITO JUDICIAL EN CRIMINOLOGÍA
INTRODUCCIÓN
BLOQUE I. CARACTERIZACIÓN GENERAL DEL PROCESO EN
ESPAÑA
MÓDULO 1. FUNDAMENTOS DEL DERECHO
UNIDAD DIDÁCTICA 1. DEFINICIÓN
1. Tipos de derecho
-Derecho objetivo y derecho subjetivo
-Ramas jurídicas
UNIDAD DIDÁCTICA 2. ORDENAMIENTO JURÍDICO
1. Ordenamiento jurídico español
-Constitución
-Leyes orgánicas
-Leyes y normas con rango de ley
-Reglamentos
-Costumbre
-Principios generales del derecho
-Normas de derecho europeo
-Normas internacionales
-Papel de la jurisprudencia
2. Instituciones productoras del derecho
MÓDULO 2. CARACTERIZACIÓN DEL PODER JUDICIAL
UNIDAD DIDÁCTICA 1. ÓRDENES JURISDICCIONALES
UNIDAD DIDÁCTICA 2. PLANTA DE LA JUSTICIA ESPAÑOLA
1. Juzgados de primera instancia e instrucción y otros
2. Audiencias Provinciales
3. Audiencia Nacional
4. Tribunales Superiores de Justicia
5. Tribunal Supremo
6. Tribunal Constitucional
7. Tribunales europeos: TJUE y TEDH
MÓDULO 3. NOCIONES BÁSICAS DE DERECHO PROCESAL
UNIDAD DIDÁCTICA 1. PRINCIPIOS DEL PROCESO JUDICIAL
UNIDAD DIDÁCTICA 2. LEY DE ENJUICIAMIENTO CIVIL
1. Esquema básico del proceso civil
UNIDAD DIDÁCTICA 3. LEY DE ENJUICIAMIENTO CRIMINAL
1. Dinámica esencial del proceso penal
RESUMEN
AUTOEVALUACIÓN
MÓDULO 4. INTRODUCCIÓN AL DERECHO CIVIL
UNIDAD DIDÁCTICA 1. CONCEPTO
1. El derecho civil en España
UNIDAD DIDÁCTICA 2. CAPACIDAD JURÍDICA Y CAPACIDAD DE OBRAR
UNIDAD DIDÁCTICA 3. CAPACIDAD PROCESAL Y LEGITIMACIÓN
UNIDAD DIDÁCTICA 4. DERECHO DE FAMILIA
1. Filiación, patria potestad y otras formas de protección de menores
2. Matrimonio y divorcio
RESUMEN
AUTOEVALUACIÓN
MÓDULO 5. PROCEDIMIENTOS DECLARATIVOS EN EL ORDEN CIVIL
UNIDAD DIDÁCTICA 1. ESQUEMA INTRODUCTORIO
UNIDAD DIDÁCTICA 2. PROCEDIMIENTO DECLARATIVO VERBAL
1. Interposición de la demanda
2. Admisión y contestación
3. Vista y sentencia
UNIDAD DIDÁCTICA 3. PROCEDIMIENTO DECLARATIVO ORDINARIO
1. Interposición de la demanda
2. Admisión
3. Contestación a la demanda
4. Audiencia previa
5. Juicio
6. Sentencia
UNIDAD DIDÁCTICA 4. SISTEMA DE RECURSOS
1. Recurso de reposición
2. Recurso de revisión
3. Recurso de apelación
4. Recurso de casación
5. Recurso de queja
RESUMEN
AUTOEVALUACIÓN
MÓDULO 6. INTRODUCCIÓN AL DERECHO PENAL
UNIDAD DIDÁCTICA 1. NOCIONES BÁSICAS
UNIDAD DIDÁCTICA 2. PRINCIPIOS DEL DERECHO PENAL
1. Principio de legalidad
2. Principio de proporcionalidad
3. Principio de ultima ratio
4. Principio de intervención mínima
5. Principio de relatividad espacio-temporal
UNIDAD DIDÁCTICA 3. HISTORIA Y CODIFICACIÓN DEL DERECHO
PENAL
1. El Código Penal español de 1995
UNIDAD DIDÁCTICA 4. TEORÍA DEL DELITO
1. Elementos del delito
2. Clasificación de los delitos
3. Responsables del delito
UNIDAD DIDÁCTICA 5. CONSECUENCIAS DEL DELITO
1. Teorías de la pena
-Teoría retribucionista
-Teoría de la prevención general
-Teoría de la prevención especial
2. Clases de sanciones penales en España
-Penas
-Medidas de seguridad
3. Responsabilidad civil derivada de delito
4. Eximentes y atenuantes
5. Agravantes
UNIDAD DIDÁCTICA 6. DERECHO PENITENCIARIO
1. Clasificación penitenciaria en España
2. Tratamiento penitenciario
RESUMEN
AUTOEVALUACIÓN
MÓDULO 7. PROCEDIMIENTO PENAL ORDINARIO
UNIDAD DIDÁCTICA 1. INDICACIONES BÁSICAS
UNIDAD DIDÁCTICA 2. FASE SUMARIAL
1. Denuncia
2. Querella
3. Actuaciones de la policía judicial
4. Instrucción del sumario
-Autoridades competentes
-Formación del sumario
5. Comprobación del delito
-Inspección ocular
-Cuerpo del delito
-Destrucción y realización anticipada de los efectos judiciales
-Identidad y circunstancias del delincuente
-Declaraciones de los procesados
-Declaraciones de los testigos
-Careo de testigos y procesados
-Informe pericial
6. Citación
7. Detención
8. Prisión provisional
9. Medidas limitativas del artículo 18 de la Constitución
-Entrada y registro
-Registro de libros y papeles
-Detención y apertura de correspondencia
-Interceptación de las comunicaciones telefónicas y telemáticas
10. Fianzas y embargos
11. Responsabilidad civil de terceros
12. Conclusión del sumario
13. Sobreseimiento
UNIDAD DIDÁCTICA 3. FASE DE JUICIO ORAL
1. Calificación del delito
2. Artículos de previo pronunciamiento
3. Celebración del juicio oral
-Publicidad de los debates
-Facultades del presidente del tribunal
-Práctica de pruebas
-Acusación y defensa
-Sentencia
-Suspensión del juicio oral
UNIDAD DIDÁCTICA 4. FASE DE RECURSOS
1. Recurso de apelación
2. Recurso de casación
-Procedencia
-Preparación
-Interposición
-Sustanciación
-Decisión
3. Recurso de revisión
RESUMEN
AUTOEVALUACIÓN
BLOQUE II. DESCRIPCIÓN GENERAL DEL DESEMPEÑO PERICIAL
MÓDULO 8. INTRODUCCIÓN AL PERITAJE
UNIDAD DIDÁCTICA 1. CONCEPTO
1. Evolución histórica del peritaje
UNIDAD DIDÁCTICA 2. JUSTIFICACIÓN
1. Resolución de litigios
2. Determinación de las causas de un siniestro
3. Evaluación de daños
4. Asesoramiento técnico
5. Autentificación de obras de arte y antigüedades
6. Examen de las condiciones de seguridad y salud
7. Valoración de la competencia profesional
8. Cuantificación de la calidad de un producto
9. Determinación de la causa de la muerte
UNIDAD DIDÁCTICA 3. PERITAJE Y TASACIÓN
1. Definición de tasación
-Tasación pericial
2. Diferencias entre peritaje y tasación
RESUMEN
AUTOEVALUACIÓN
MÓDULO 9. FIGURA PROFESIONAL DEL PERITO
UNIDAD DIDÁCTICA 1. DEFINICIÓN
1. Competencias profesionales
2. Tipos de peritos
-Perito forense
-Perito médico
-Perito psicólogo
-Perito grafólogo
-Perito contable
-Perito informático
-Perito ingeniero
-Perito ambiental
-Perito tasador
3. Derechos
4. Obligaciones
5. Código deontológico
UNIDAD DIDÁCTICA 2. CARACTERIZACIÓN LEGAL DEL PERITO
1. Peritos en la LEC
-Condiciones
-Causas de abstención y recusación
2. Peritos en la LECrim
-Clases
-Causas de recusación
UNIDAD DIDÁCTICA 3. RESPONSABILIDADES CIVIL Y PENAL DEL
PERITO
1. Responsabilidad civil
-Incumplimientos relacionados con la emisión del dictamen
-Incumplimientos en la fase de juicio y ratificación
2. Responsabilidad penal
RESUMEN
AUTOEVALUACIÓN
MÓDULO 10. ACTIVIDAD PROBATORIA EN SEDE JUDICIAL
UNIDAD DIDÁCTICA 1. CONCEPTO Y OBJETO DE LA PRUEBA
1. Necesidad de la prueba
2. Iniciativa
3. Impertinencia o inutilidad
UNIDAD DIDÁCTICA 2. MEDIOS DE PRUEBA
1. Interrogatorio de las partes
2. Documentos públicos
3. Documentos privados
4. Dictamen de peritos
5. Reconocimiento judicial
6. Interrogatorio de testigos
-Dinámica del interrogatorio
7. Reproducción de medios audiovisuales
UNIDAD DIDÁCTICA 3. VALORACIÓN DE LA PRUEBA
1. Tipos de valoración
-Valoración legal
-Valoración libre
2. Premisas para la valoración
-Fijación adecuada de la controversia
-Recopilación correcta de la prueba
-Participación del juez en la prueba
3. Motivación de la valoración
4. Impugnación de la valoración
-Impugnación en las conclusiones
-Impugnación en la apelación
-Impugnación en la casación
RESUMEN
AUTOEVALUACIÓN
MÓDULO 11. DICTAMEN PERICIAL EN EL PROCESO CIVIL
UNIDAD DIDÁCTICA 1. CONCEPTO DE DICTAMEN PERICIAL
1. Objeto y finalidad
UNIDAD DIDÁCTICA 2. APORTACIÓN DE DICTÁMENES
1. Aportación con la demanda y con la contestación
2. Aportación posterior
3. Aportación en vista de las actuaciones procesales
UNIDAD DIDÁCTICA 3. INTERVENCIÓN EN EL PROCEDIMIENTO
1. Solicitud de intervención
2. Solicitud de designación
3. Llamamiento y aceptación
4. Operaciones periciales
5. Emisión y ratificación del dictamen
6. Actuación en el juicio o en la vista
RESUMEN
AUTOEVALUACIÓN
MÓDULO 12. INFORME PERICIAL EN EL PROCESO PENAL
UNIDAD DIDÁCTICA 1. CONCEPTO DE INFORME PERICIAL
1. Justificación
UNIDAD DIDÁCTICA 2. CONTENIDO DEL INFORME PERICIAL
1. Descripción de la materia de análisis
2. Relación de las operaciones realizadas
3. Conclusiones
UNIDAD DIDÁCTICA 3. INTERVENCIÓN EN EL JUICIO ORAL
RESUMEN
AUTOEVALUACIÓN
MÓDULO 13. EL PERITO EN LA MEDIACIÓN
UNIDAD DIDÁCTICA 1. DEFINICIÓN DE MEDIACIÓN
1. Objetivos
2. Principios
3. Figura del mediador
-Cualidades
UNIDAD DIDÁCTICA 2. MARCO LEGAL EN ESPAÑA
UNIDAD DIDÁCTICA 3. FASES DE LA MEDIACIÓN
1. Solicitud de inicio
2. Información y sesiones informativas
3. Sesión constitutiva
4. Desarrollo de las actuaciones
5. Terminación del procedimiento
6. Aprobación del acuerdo de mediación
UNIDAD DIDÁCTICA 4. PAPEL DEL PERITO EN LA MEDIACIÓN
RESUMEN
AUTOEVALUACIÓN
MÓDULO 14. INTERVENCIÓN DEL PERITO EN EL ARBITRAJE
UNIDAD DIDÁCTICA 1. APROXIMACIÓN AL ARBITRAJE
1. Convenio arbitral
2. Caracterización del árbitro
-Nombramiento de los árbitros
-Abstención y recusación de los árbitros
-Responsabilidad de los árbitros
UNIDAD DIDÁCTICA 2. FASES DEL ARBITRAJE
1. Firma del convenio arbitral
2. Sustanciación de las actuaciones arbitrales
-Actuación de peritos
-Asistencia judicial
3. Pronunciamiento del laudo y terminación de las actuaciones
4. Anulación y revisión del laudo
5. Ejecución forzosa del laudo
RESUMEN
AUTOEVALUACIÓN
BLOQUE III. ESPECIALIZACIÓN PERICIAL EN CRIMINOLOGÍA
MÓDULO 15. CRIMINOLOGÍA Y PSICOLOGÍA CRIMINAL
UNIDAD DIDÁCTICA 1. CONCEPTOS
UNIDAD DIDÁCTICA 2. TEORÍAS SOBRE LA CONDUCTA CRIMINAL
UNIDAD DIDÁCTICA 3. PERFIL PSICOLÓGICO DEL CRIMINAL
UNIDAD DIDÁCTICA 4. PERFIL PSICOLÓGICO DE LA VÍCTIMA
MÓDULO 16. EVALUACIÓN PSICOLÓGICA EN CRIMINOLOGÍA
UNIDAD DIDÁCTICA 1. NOCIONES BÁSICAS
UNIDAD DIDÁCTICA 2. EVALUACIÓN DE LA INTELIGENCIA
UNIDAD DIDÁCTICA 3. EVALUACIÓN DE LA PERSONALIDAD
UNIDAD DIDÁCTICA 4. EVALUACIÓN DE LA CAPACIDAD DE ATENCIÓN Y CUIDADO
UNIDAD DIDÁCTICA 5. MEDICIÓN DE CARACTERES
PSICOPATOLÓGICOS
UNIDAD DIDÁCTICA 6. ESTUDIO DE LA SIMULACIÓN
UNIDAD DIDÁCTICA 7. HERRAMIENTAS DE EVALUACIÓN EN
NEUROPSICOLOGÍA
MÓDULO 17. PERICIAS PSICOLÓGICAS EN LA JURISDICCIÓN PENAL
UNIDAD DIDÁCTICA 1. IMPUTABILIDAD
UNIDAD DIDÁCTICA 2. CIRCUNSTANCIAS EXIMENTES Y ATENUANTES
UNIDAD DIDÁCTICA 3. EVALUACIÓN DEL RIESGO Y DE LA
PELIGROSIDAD
MÓDULO 18. PERICIAS PSICOLÓGICAS EN PROCESOS CON
MENORES
UNIDAD DIDÁCTICA 1. BASES DEL SISTEMA LEGAL DE PROTECCIÓN A LA INFANCIA Y LA ADOLESCENCIA
UNIDAD DIDÁCTICA 2. EVALUACIÓN DE LOS MENORES VÍCTIMAS
UNIDAD DIDÁCTICA 3. EVALUACIÓN DE LOS MENORES INFRACTORES
Información adicional
*El contenido del curso se encuentra orientado hacia la adquisición de formación teórica complementaria. Este curso no conduce a la obtención de una titulación oficial.
¿Necesitas un coach de formación?
Te ayudará a comparar y elegir el mejor curso para ti y a financiar tu matrícula en cómodos plazos.
MÁSTER EN EPIDEMIOLOGÍA Y PREVENCIÓN DE ENFERMEDADES






